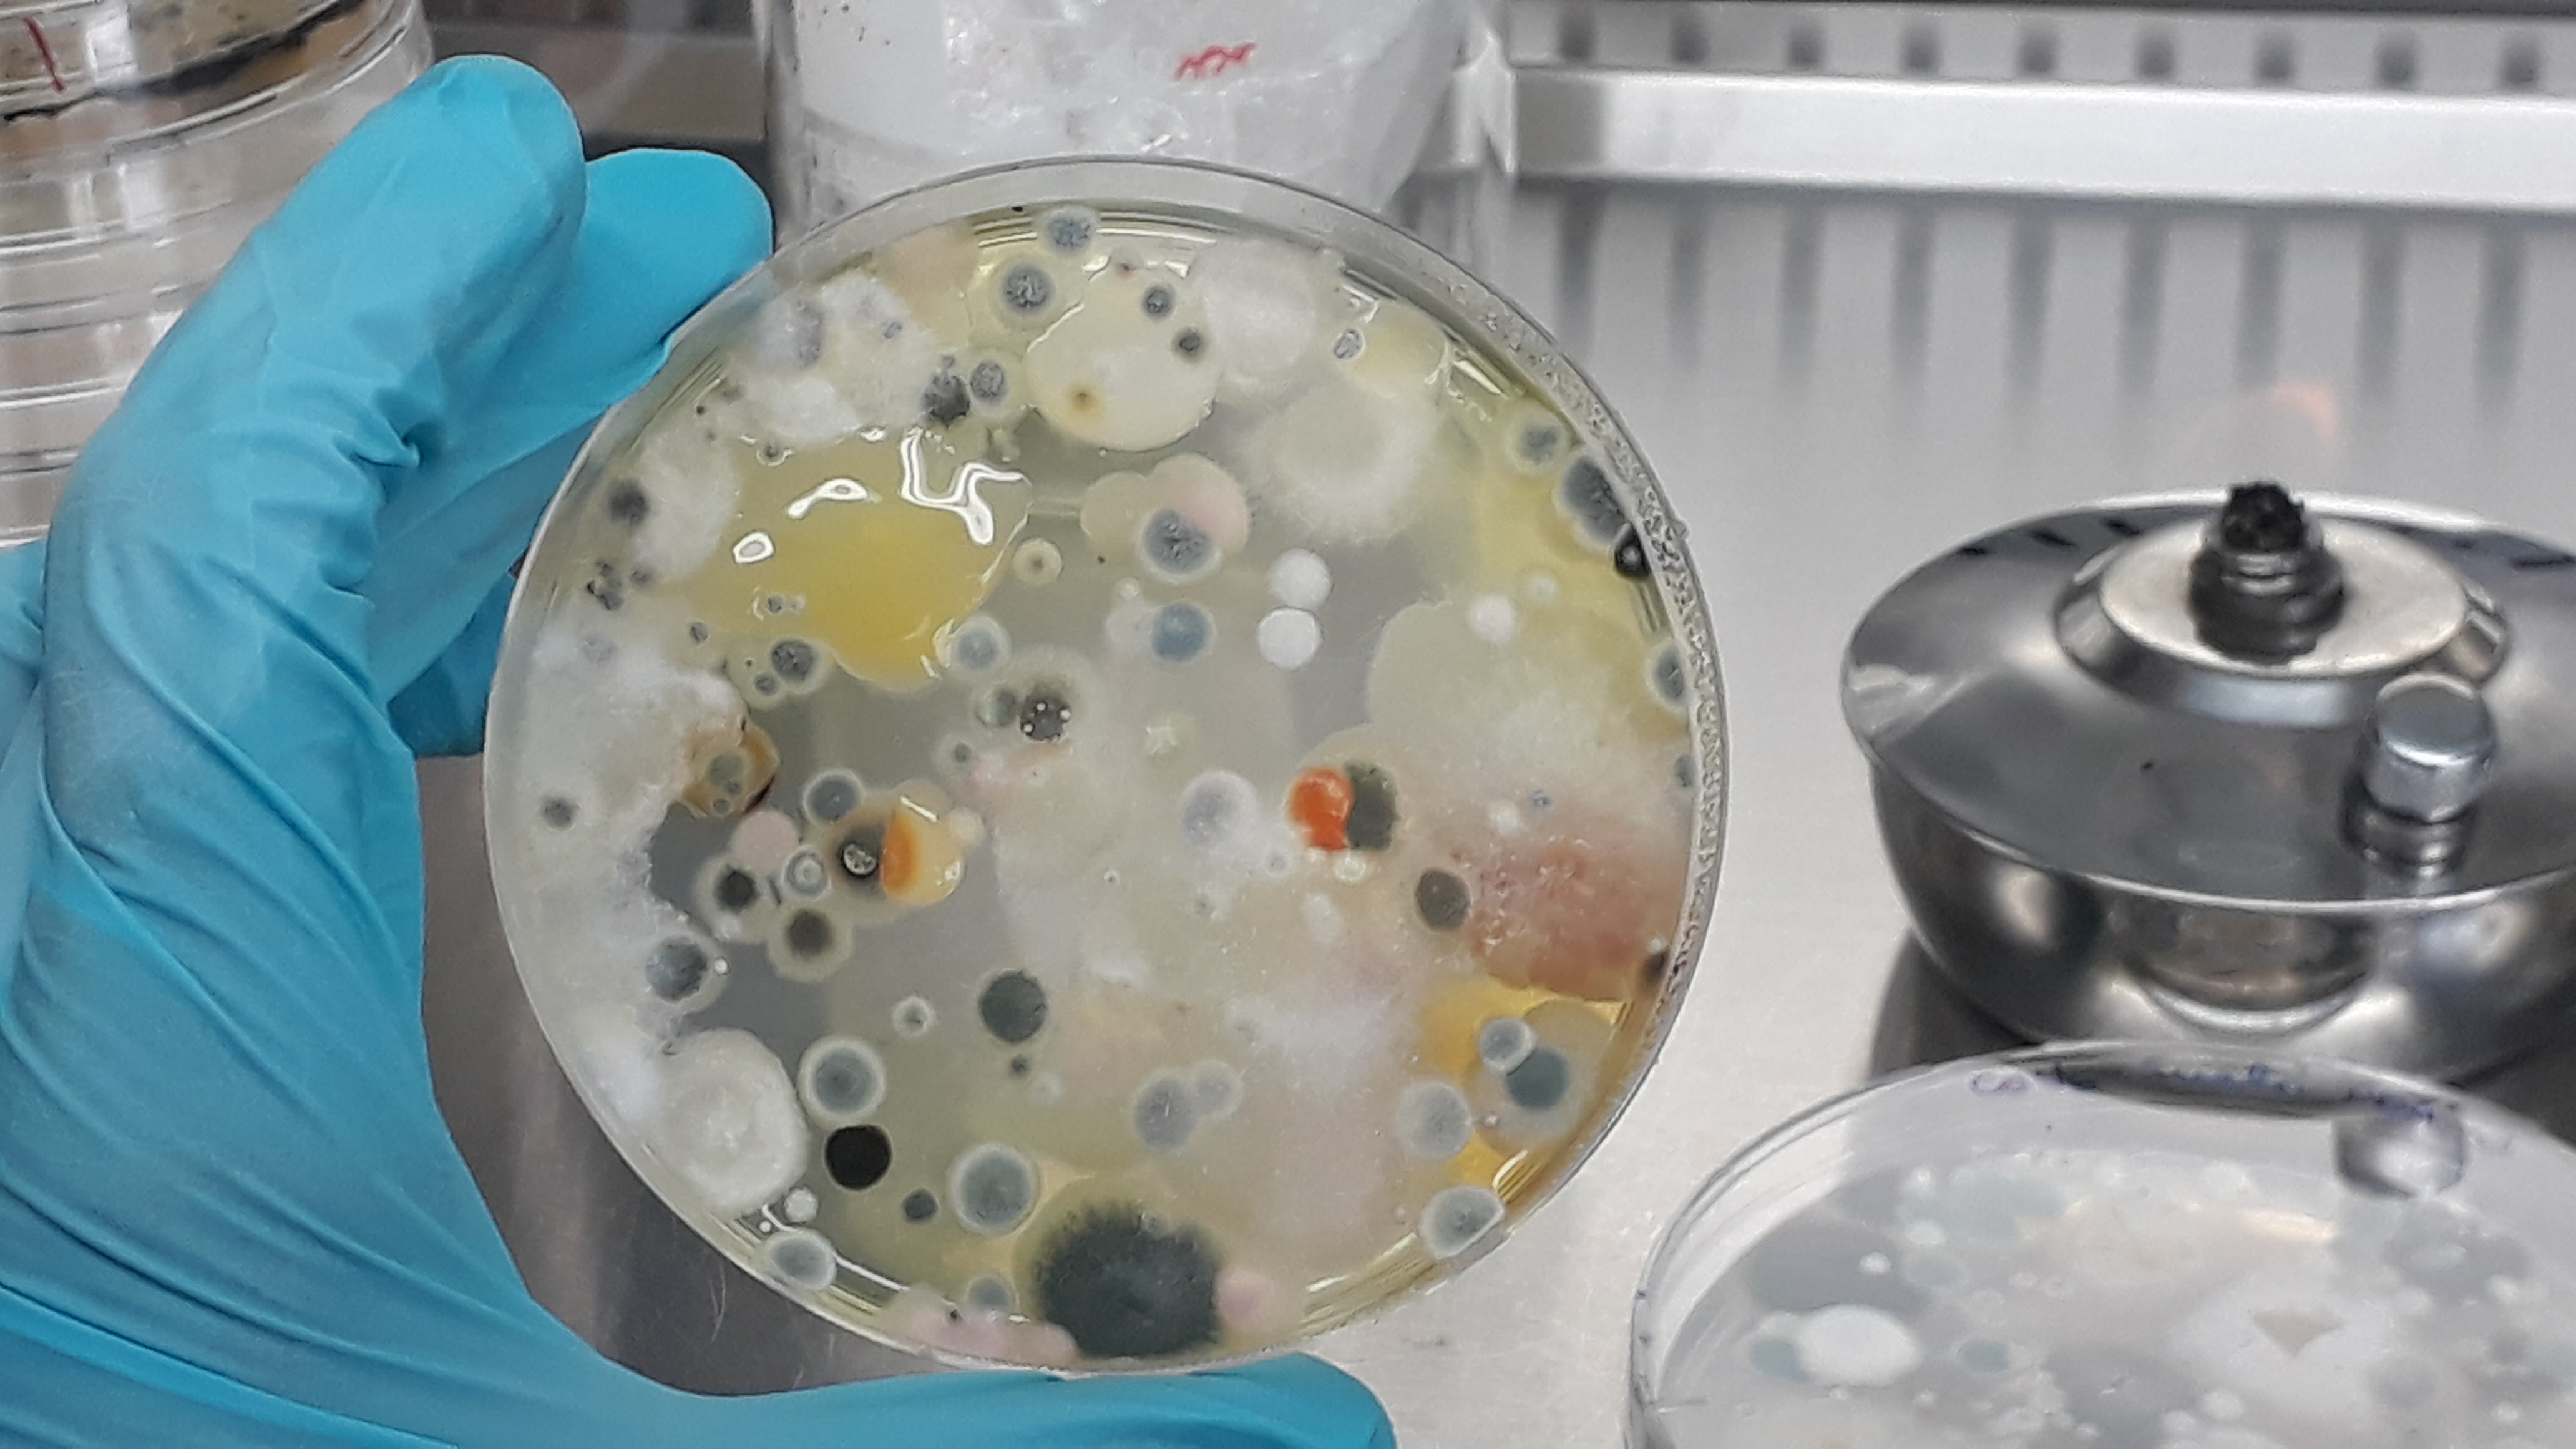

Hello, I am

I am a Biochemist, Microbiologist, and Designer.
I have worked with the University of California Davis, the University of British Columbia, Agriculture & AgriFood Canada, and others to find patterns and solutions against Grapevine Trunk Diseases.
Currently, I am doing my Ph.D. on predicting pathogen transmission between plants, determining the variables that influence how severe a new infection could be.
Working with the Industry and Academia
Career & Awards
Even though I am currently dedicated to building models to predict disease transmission and severity, I have done other things. Take a look.
Presentations &
Communication
Science is to be communicated and shared with everyone. See where I have presented my work and how we can improve our
Publications
I have worked with the industry and the academia. We need to connect both to get the best solutions. Take a look at my latest publications.

I have worked in Labs in several countries, and I have learned a lot not only from the science they are doing but also about culture, social relations, and teammaking. I have always thought that teams are essential. A single cell might be able to do amazing things and perform unbelievable tasks, but never at the level of a multicellular organism.
Teaching and Design
I have always loved making handcrafts and art/design-related things. Even though I love science and am always curious about how things work, I have always had a side project: embroidery, painting, cooking, sculpting, ceramics, beads… and that balances my life in many ways. So, here are some of my side projects.